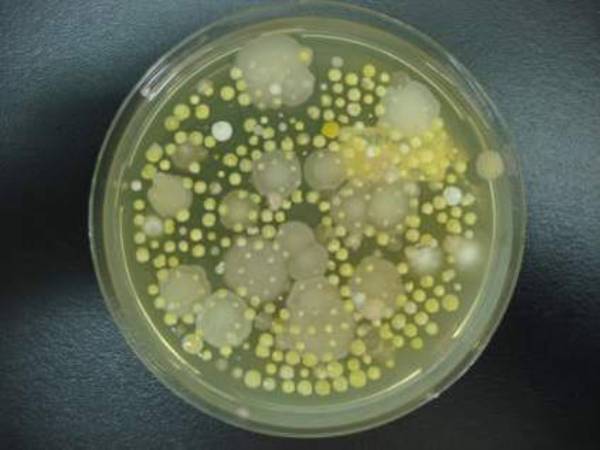

您的服務清單沒有加入任何項目
實驗室儀器設備
|
GBCAA
中央檢驗室
中央檢驗室-滴定法
中央檢驗室-重量法
儀器室
加熱室-CN萃取區
加熱室-油脂萃取區
天平區
廢棄物室
微生物室
總菌落數
藥品室
|
| 台南總公司:717臺南市仁德區忠義二街25號巷6號 | TEL:06-249-1118 | FAX:06-2491239 | Email:jxe001@gmail.com |
| 網站維護者:嘉興環境科技有限公司 訪客數:00390737
|
|||
| Copyright © 2011-2012 by JXE. All Rights Reserved 嘉興環境科技有限公司所有 | |||